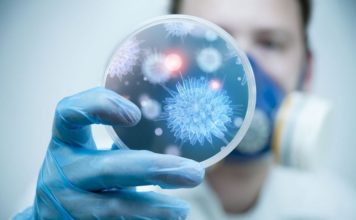

Двое медиков, пострадавших на пожаре в запорожской больнице, госпитализированы (ФОТО)
Два сотрудника Запорожской областной инфекционной больницы - врач-анестезиолог Антон Климов и медбрат Александр Симин пострадали во время пожара и были госпитализированы в 5-ю горбольницу....
Запорожцев приглашают стать участниками марафона здоровых привычек
В Украине стартовал марафон здоровых привычек под хэштегами #ЗдороваУкраина и #ЖивуЗдорово. Это совместная инициатива Всемирной организации здравоохранения, Министерства здравоохранения Украины и Центра общественного здоровья.
-...
В Запоріжжі пацієнт лікарні знову навчився ходити заради коханої
Його мрія проста й водночас велика: здійснити обіцянку, дану дружині, — звозити її до океану. Саме заради цього Владислав Григорович має повністю одужати та...
На рынках в Запорожской области выявили сотни килограммов некачественной молочной продукции
Ветеринарные лаборатории Мелитополя проводят регулярные проверки качества продукции, реализуемой на рынках города. Сегодня, 14 декабря, стало известно, что за последний месяц специалисты изъяли с...
Во сколько обойдется лечение коронавируса в Украине: названы суммы
На бесплатное лечение украинцев от COVID-19 государство попросту не выделило денег. Об этом сообщает "Страна" со ссылкой на собственные источники в медицинских кругах.
Те, кто...
Шість пацієнтів за тиждень зустріли новий світанок життя завдяки трансплантологам Запорізької обласної клінічної лікарні
Це був надзвичайний тиждень – новий світанок свого життя зустрічають 6 пацієнтів, які роками очікували на донорський орган. Шість різних людських шляхів, шість родин,...
В Запорізькій обласній лікарні навчились успішно долати «делікатну» проблему
Геморой – це та болюча тема, про яку не заведено говорити вголос. Але досить обмежувати себе через болі та дискомфорт! Спеціалісти Запорізької обласної лікарні...
Официальная информация: половину запорожских школ закрыли на карантин
По состоянию на 12 февраля в Запорожской области полностью прекращено обучение детей в 282 школах региона (53%). Также частично приостановлен учебный процесс в 21-м...
В Запорожской области — повышенная опасность поражения молнией
В Запорожской области ГСЧС объявила 1-й "жёлтый" уровень грозовой опасности. В связи с этим спасатели предупреждают о правилах безопасности в такой ситуации.
Во время...
Запорожские пляжи небезопасны для отдыхающих
Сотрудники Лабораторного центра МОЗ в Запорожской области продолжают мониторинг состояния воды на городских пляжах. Стало известно, где горожанам купаться небезопасно.
По информации специалистов лабцентра, пробы...